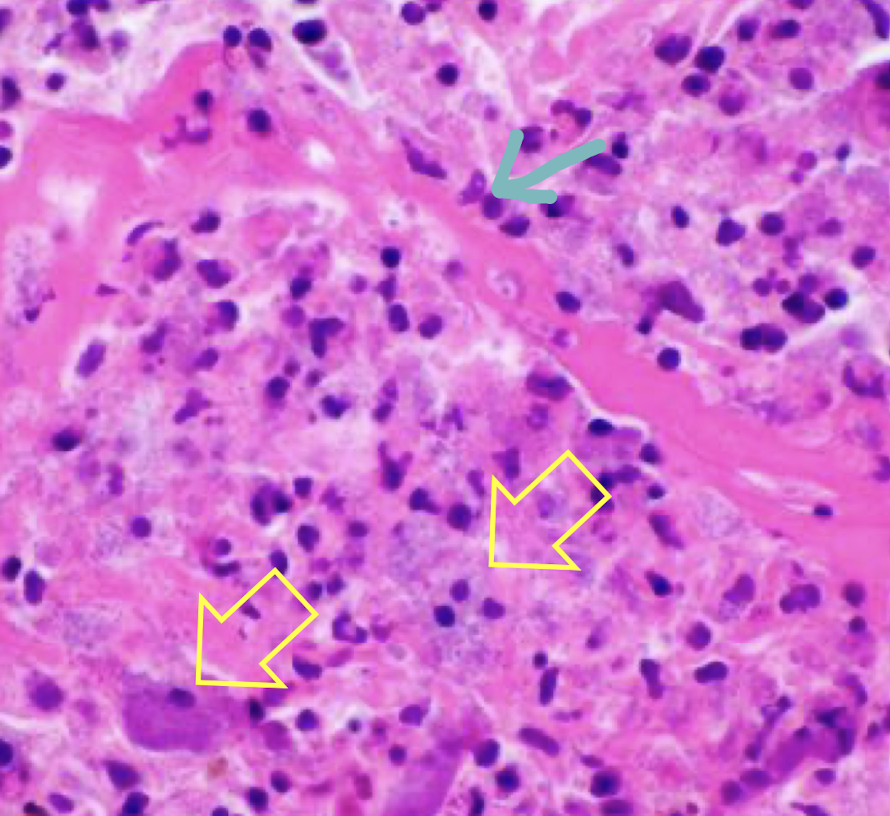

What are the 7 steps in microbial disease?
What are the possible cell outcomes / mechanisms of injury?
Will inflammation occur with any of the possible cell outcomes?
Inflammation may occur along with many cell outcomes.
What is the scientific name of Pisttacosis?
Chlamydophila (Chlamydia) psittaci
What kind of bacteria is Chlamydophila (Chlamydia) psittaci? How does it survive?
What is the mechanisms of injury for psittacosis?
Mechanisms of injury:
What is the pathogenesis of psittacosis?
Elementary Bodies enter cells via endocytosis or phagocytosis
What is the purpose of elementary bodies? Reticular bodies?
Elementary bodies are more hardy, can be used to infect or leave cells. They cannot reproduce though, that is only done by the reticular bodies.
Why is psittacosis significant? What Birds are known to be the highest infected?
What is the transmission route of psittacosis? What is important about the bacteria in the environment. What kind of disease can it cause in humans?
Transmission:
- Via respiratory droplets, feather dust,
feces
- Inhalation, ingestion or mucosal
(conjunctival) contact
-Survives desiccation
In humans Respiratory disease may be severe, even if you are not immunocompromised you can get bad pneumonia.
What is a way that psittacosis can be aerosolized?
What is occuring in this histological image of a bird liver? What is the condition associated with it?

Psittacosis - Necrosis ( coagulative necrosis -> still has some cell shape/ sinus outlines)

What is another name for psittacosis?
Pirates disease
What is the morphologic diagnosis of this gross image? What condition has gross morphology like this?

Acute, severe, multifocal necrotizing hepatitis.
You can also say -> acute diffuse severe fibronous pericarditis.
Psittacosis
What is the morphologic diagnosis of this histological slide? What is a likely etiologic diagnosis?

Acute severe heterophilic necrotizing multifocal hepatitis
Etiological diagnosis: Bacterial hepatitis
What is being indicated by the yellow arrows? The blue arrow?
Yellow arrow: macrophages with unicellular debris.
Blue arrow: Dead heterophils
What is one way to diagnose Psittacosis? What is the most ideal way to diagnose it?
You can do a gram stain to see if it is a gram negative bacteria. Since you cant differentiate it from another gram negative bacteria you should use, machiavelli stain, since the elementary bodies will apear a periwinkle color. To be 100% sure you must use IHC or In situ hybridization.
What stain is depicted here for this gram negative bacteria? What is the bacteria and what can be seen in this image?

Machiavelli stain - you will see elementary bodies staining a periwinkle color. This is psittacosis.
What is the brown around this cell indicating? What kind of stain is this? What is it usually used in?

This is IHC. The brown is the target which shows your histology is positive. This is positive for psittacosis.
What birds are affected by avian pox?
Any bird species can be affected by Avian pox.
> 200 bird species are susceptible
What kind of virus is avian pox?
Genus Avipoxvirus of the Poxviridae
- DS DNA enveloped
What is this stain and what is it highlighting? What in this stain is the bright pink areas?

This is a gram stain, and the bright pink ares are showing the gram negative bacteria in this sample of tissue.
What is the route of transmission for avian pox?
Transmission:
- Insect bites, skin lacerations
What forms of avian pox are there? What is most common?
Dry form is the most common